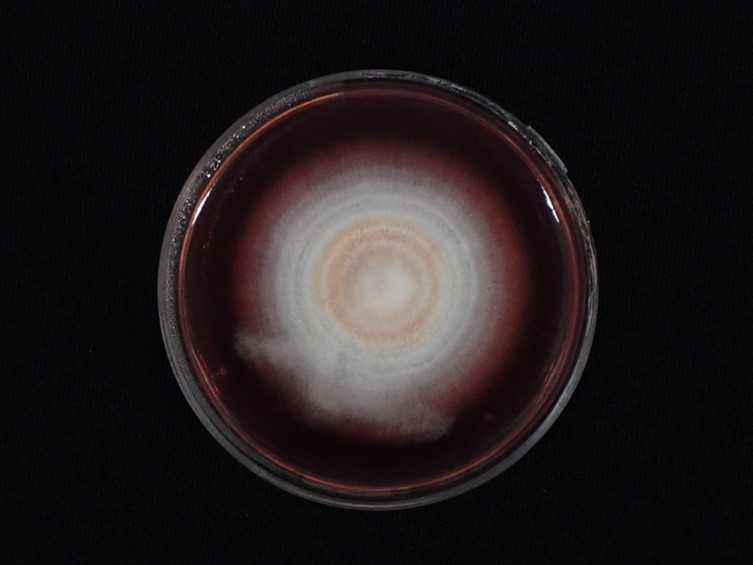

Holotype:
THAILAND, Nakhon Ratchasima Province, Khao Yai National Park, 5 Aug. 2010, K. Tasanathai, P. Srikitikulchai, S. Mongkolsamrit, A. Khonsanit, R. Somnuk, K. Sansatchanon, holotype BBH 30157, ex-type living culture BCC 43741.
Habitat:
Living stems of dicotyledonous plant
Host:
Scale insects (Coccidae; Hemiptera).
Description:
 Stromata epibiotic, flattened to convex, cylindrical to irregularly shaped, upper surface very pale violet to dark purple, lower surface white to pale orange, 3-25 mm wide, 1-3 mm thick.
Stromata epibiotic, flattened to convex, cylindrical to irregularly shaped, upper surface very pale violet to dark purple, lower surface white to pale orange, 3-25 mm wide, 1-3 mm thick.  Perithecia semi-immersed, slightly protruding apices, narrow flask shaped, slightly protruding, obclavate, 300-360 × 100-120 μm.
Perithecia semi-immersed, slightly protruding apices, narrow flask shaped, slightly protruding, obclavate, 300-360 × 100-120 μm.  Asci cylindrical, up to 215 μm. long, 3-4 μm. wide. Asci caps 2-4 × 3-4 μm.
Asci cylindrical, up to 215 μm. long, 3-4 μm. wide. Asci caps 2-4 × 3-4 μm.  Ascospores hyaline, whole, filiform, aseptate, 175-200 × 1 μm.
Ascospores hyaline, whole, filiform, aseptate, 175-200 × 1 μm.
Culture characteristics:
Colony on PDA attaining a diam of 3–4 cm in 14 d, cottony, white, pale orang in the middle of colony, reverse dark red in the middle, bright strong purplish red pigment diffusing in medium. Phialides arising from aerial hyphae, solitary, cylindrical or acremonium-like, up to 50 μm long, 1–2 μm wide. Conidia hyaline, enteroblastic, fusiform to acerose, early in development aseptate, mostly becoming 1 septum, occasionally 2–3 septa, aggregated at the apex of the phialides, 7–22 × 1.5–3 μm.
Colony on PDA attaining a diam of 3–4 cm in 14 d, cottony, white, pale orang in the middle of colony, reverse dark red in the middle, bright strong purplish red pigment diffusing in medium. Phialides arising from aerial hyphae, solitary, cylindrical or acremonium-like, up to 50 μm long, 1–2 μm wide. Conidia hyaline, enteroblastic, fusiform to acerose, early in development aseptate, mostly becoming 1 septum, occasionally 2–3 septa, aggregated at the apex of the phialides, 7–22 × 1.5–3 μm.
Reference:
Thanakitpipattana D, Mongkolsamrit S, Khonsanit A, et al. (2022). Is Hyperdermium Congeneric with Ascopolyporus? Phylogenetic Relationships of Ascopolyporus spp. (Cordycipitaceae, Hypocreales) and a New Genus Neohyperdermium on Scale Insects in Thailand. Journal of Fungi 8: 516.
DOI: https://doi.org/10.3390/jof8050516Species |
Strain |
Compound |
Pubchem CID |
Biological activity |
Reference |
|---|
|
Strain |
LSU | RPB2 | TEF1 |
|---|---|---|---|
| BCC 43314 | OL322052 | OL322069 | OL322039 |
| BCC 43741 | OL322041 | OL322070 | OL322040 |